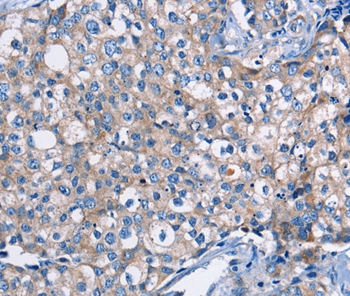
产品细节图片1

相关产品推荐更多 >
万千商家帮你免费找货
0 人在求购买到急需产品
- 详细信息
- 文献和实验
- 技术资料
- 免疫原:
Fusion protein corresponding to residues near the C terminal of human dystrophin
- 形态:
liquid
- 保存条件:
Store at -20˚C
- 克隆性:
Polyclonal
- 适应物种:
Human
- 保质期:
12 months
- 抗原来源:
Rabbit
- 供应商:
南京赛戈巍生物科技有限公司
- 宿主:
Rabbit
- 应用范围:
IHC
- 靶点:
Uniprot:P11532
- 抗体英文名:
DMD Antibody
- 规格:
50ul/100ul
配方:Rabbit IgG in pH7.3 PBS, 0.05% NaN3, 50% Glycerol.
应用详情:Immunohistochemistry: 1:25-1:100
图片:
Immunohistochemical analysis of paraffin-embedded Human breast cancer tissue using #36428 at dilution 1/30.
,

Immunohistochemical analysis of paraffin-embedded Human brain tissue using #36428 at dilution 1/30.
风险提示:丁香通仅作为第三方平台,为商家信息发布提供平台空间。用户咨询产品时请注意保护个人信息及财产安全,合理判断,谨慎选购商品,商家和用户对交易行为负责。对于医疗器械类产品,请先查证核实企业经营资质和医疗器械产品注册证情况。
文献和实验杜氏进行性肌营养不良(Duchenne muscular dystrophy,DMD)和贝氏进行性肌营养不良(Becker muscular dystrophy,BMD)系X连锁隐性遗传病,是由于抗肌萎缩蛋白(dystrophin)基因突变所致的肌源性损伤。基因突变的主要类型是基因片段缺失,在基因5‘端和3’端分别存在一个缺失高发区,尤其后者,以外显子51区域为高峰医学|教育网整理搜集,中国人病例近80 %的缺失突变发生在此区域。其中大范围(一个或数个外显子) 缺失型占60 % ,重复型
Systemic Delivery of Antisense Oligomer in Animal Models and Its Implications for Treating DMD
Antisense oligomer (AO)-mediated splicing modulation for treating DMD demands a systemic administration of AOs as pharmacological drugs to achieve effective prevention of disease progression and to improve quality and longevity of patient
Duchenne muscular dystrophy (DMD) is an X-linked recessive neuromuscular disorder caused by mutations in the dystrophin gene at Xp21. Approximately two-thirds of the mutations are intragenic deletions of one or more of the 79 exons
技术资料暂无技术资料 索取技术资料





![ZMYM5 Antibody[39585]](https://img1.dxycdn.com/p/s14/2025/0922/359/6146153295428599691.jpg!wh200)
![OCT-1 Polyclonal Antibody FITC Conjugated[C90581FITC]](https://img1.dxycdn.com/p/s14/2025/0922/498/0460884283108299691.jpg!wh200)
![DHRS7B Conjugated Antibody[C31902]](https://img1.dxycdn.com/p/s14/2025/0923/305/2150219664296040791.jpg!wh200)

